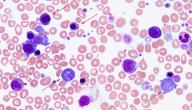

محتويات
- ١ مكونات الدم
- ٢ كريات الدم البيضاء
- ٣ أنواع كريات الدم البيضاء
- ٤ ارتفاع كريات الدم البيضاء في الجسم
- ٥ أسباب ارتفاع كريات الدم البيضاء في الجسم
- ٦ أعراض ارتفاع كريات الدم البيضاء في الجسم
- ٧ كيف يتم التحضير للكشف عن عدد كريات الدم البيضاء في الجسم
- ٨ كيف يتم الكشف عن عدد كريات الدم البيضاء في الجسم
- ٩ مضاعفات الكشف عن عدد كريات الدم البيضاء في الجسم
- ١٠ تشخيص ارتفاع كريات الدم البيضاء في الجسم
- ١١ علاج ارتفاع كريات الدم البيضاء في الجسم
- ١٢ الوقاية من ارتفاع كريات الدم البيضاء في الجسم
مكونات الدم
الدم عبارة عن سائل لزج له العديد من الوظائف كنقل الأكسجين والغذاء من القلب إلى أعضاء الجسم المختلفة، ونقل ثاني أكسيد الكربون والنفايات من أعضاء الجسم إلى الرئتين والكلية، وذلك للتخلص منهم، ويتكون الدم من البلازما والتي تشكل 55% من مكونات الدم، وأيضًا يتكون الدم من كريات الدم الحمراء وكريات الدم البيضاء والصفائح الدموية وكل تلك المكونات تشكل النسبة المتبقية من الدم وهي 44%، وكريات الدم البيضاء تشكل 1% فقط من مكونات الدم وتساعد على محاربة الأمراض، وقد يحدث ارتفاع في كريات الدم البيضاء في الجسم نتيجة العديد من الأسباب، وسيتم توضيح أسباب ارتفاع كريات الدم البيضاء في الجسم لاحقًا.[١]
كريات الدم البيضاء
كريات الدم البيضاء هي إحدى مكونات الدم ويقوم الجسم بإنتاجها لمكافحة الالتهابات، ويوجد عدة أنواع لكريات الدم البيضاء كالخلايا اللمفاوية أو العدلات، والخلايا اللمفاوية يتم إنتاجها في الطحال أو في الغدد اللمفاوية، وتعمل على إفراز أجسام مضادة، وهذه الأجسام تعمل على قتل البكتيريا أو الفيروسات، أما العدلات فيتم إنتاجها في نخاع العظم، وأيضًا تعمل على قتل البكتيريا والفيروسات، وتجدر الإشارة إلى أن عدد كريات الدم البيضاء الطبيعي يتراوح ما بين 4000 إلى 11000 خلية لكل ميكروليتر، وقد يحدث انخفاض أو ارتفاع في عدد كريات الدم البيضاء، وهذا الارتفاع أو الانخفاض قد يكون دليل على وجود حالة مرضية، وهذا المقال سيوضح الارتفاع في كريات الدم البيضاء، وأيضًا سيتم توضيح أسباب ارتفاع كريات الدم البيضاء في الجسم.[٢]
أنواع كريات الدم البيضاء
كريات الدم البيضاء هي جزء من الجهاز المناعي في الجسم، وتساعد على مكافحة الالتهابات وقتل البكتيريا، وأيضًا تعمل على إنتاج أجسام مضادة تساعد على حماية الجسم من التعرض لبعض الالتهابات في المستقبل، وأسباب ارتفاع كريات الدم البيضاء في الجسم عديدة، وقد تؤدي تلك الأسباب لارتفاع أي نوع من أنواع كريات الدم البيضاء، وسيتم توضيح هذه الأنواع، وهي كالآتي:[٣]
- العدلات Neutrophils: العدلات هي خط الدفاع الأول في الجهاز المناعي وتعمل على قتل البكتيريا والفيروسات، ويتم إنتاجها في النخاع العظمي، وتخرج من الجسم عن طريق الصديد، ويقوم الجسم بإنتاج 100 بليون من هذه الخلايا يوميًا وتعيش لمدة ثماني ساعات فقط، وتجدر الإشارة إلى أن هذا النوع من أنواع كريات الدم البيضاء يعادل نصف خلايا الدم البيضاء تقريبًا.
- الخلايا الحمضية Eosinophils: الخلايا الحمضية تلعب دورًا هامًا في مكافحة العدوى التي تحدث بسبب الطفيليات كالديدان، وأيضًا الخلايا الحمضية قد تؤدي في بعض الأحيان إلى حدوث فرط في استجابة جهاز المناعة لبعض المواد كحبوب اللقاح وبالتالي حدوث رد فعل تحسسي، وتجدر الإشارة إلى أن هذه الخلايا تكون متواجدة بتركيز عالي في الجهاز الهضمي.
- الخلايا القاعدية Basophils: تساعد الخلايا القاعدية في تحفيز الجهاز المناعي على محاربة الالتهابات، وأيضًا تساعد هذه الخلايا على تحفيز إنتاج الهيستامين والذي يؤدي إلى حدوث التهاب في الشعب الهوائية، وأيضًا يؤدي إلى حدوث تضيق في تلك الشعب.
- الخلايا اللمفاوية Lymphocytes: الخلايا اللمفاوية تعتبر أحد أهم أنواع كريات الدم البيضاء، وتتكون الخلايا اللمفاوية من نوعين وهم: الخلايا اللمفاوية التائية والخلايا اللمفاوية البائية، والخلايا اللمفاوية التائية تساعد على قتل الأجسام الغريبة التي تدخل الجسم، أما الخلايا اللمفاوية البائية تساعد على تحفيز وزيادة فاعلية العديد من اللقاحات كلقاح مرض السل أو لقاح مرض السعال الديكي.
- الخلايا وحيدة النواة Monocytes: تشكل هذه الخلايا من 5% إلى 12% من مكونات كريات الدم البيضاء، ووظية هذه الخلايا هي البلعمة -والبلعمة هي عبارة عن عملية يتم من خلالها التخلص من الخلايا الميتة في الجسم-.
ارتفاع كريات الدم البيضاء في الجسم
المعدل الطبيعي لكريات الدم البيضاء في الجسم يتراوح من 4000 إلى 11000 خلية لكل ميكروليتر، وعند زيادة معدل هذه الخلايا عن 11000 خلية لكل ميكروليتر فهذا يعني حدوث ارتفاع في كريات الدم البيضاء في الجسم، وأسباب ارتفاع كريات الدم البيضاء في الجسم عديدة ومنها: حدوث رد فعل تحسسي لبعض الأدوية أو التعرض لالتهابات أو التعرض لأمراض في نخاع العظم أو حدوث اضطراب في الجهاز المناعي أو التدخين أو التهاب المفاصل الروماتويدي أو مرض السل أو الإجهاد أو السعال الديكي.[٤]
أسباب ارتفاع كريات الدم البيضاء في الجسم
تعمل كريات الدم البيضاء على مكافحة الالتهابات، كما وتساعد في عملية شفاء الأنسجة التالفة، ويتم تخزين كريات الدم البيضاء في نخاع العظم، وعند تعرض الجسم لالتهاب تنتقل هذه الكريات إلى المنطقة المصابة عبر مجرى الدم، وقد يحدث ارتفاع في كريات الدم البيضاء نتيجة العديد من الأسباب، وسيتم توضيح أسباب ارتفاع كريات الدم البيضاء في الجسم، وهي كالآتي:[٥]
- العدوى: العدوى البكتيرية والعدوى الفيروسية تعتبر أكثر أسباب ارتفاع كريات الدم البيضاء في الجسم شيوعًا، وأيضًا قد تؤدي العدوى الفطرية أو العدوى الطفيلية إلى حدوث ارتفاع في عدد كريات الدم البيضاء، وتجدر الإشارة إلى أن عدد كريات الدم البيضاء يعود للمعدل الطبيعي فور اختفاء العدوى.
- الالتهابات والحساسية: التعرض لالتهابات كالتهاب المفاصل الروماتيدي أو التهاب القولون التقرحي أو مرض كرون يعتبر من أسباب ارتفاع كريات الدم البيضاء في الجسم، وأيضًا قد يحدث ارتفاع في كريات الدم البيضاء بسبب حدوث التهابات نتيجة التعرض لحروق أو نتيجة النوبات القلبية أو نتيجة إجراء عملية جراحية كبرى، كما أن التعرض لحساسية شديدة يعتبر من أسباب ارتفاع كريات الدم البيضاء في الجسم.
- الإجهاد وردود الفعل التحسسية لبعض الأدوية والتدخين: الإجهاد البدني أو العاطفي الحاد يعتبر من أسباب ارتفاع كريات الدم البيضاء في الجسم، وأيضًا حدوث رد فعل تحسسي لبعض الأدوية كالمضادات الحيوية أو الأدوية المستخدمة في علاج السرطان يعتبر من أسباب ارتفاع كريات الدم البيضاء في الجسم، كما أن التدخين قد يؤثر على عمل نخاع العظم وبالتالي حدوث زيادة في إنتاج بعض أنواع كريات الدم البيضاء.
- أمراض نخاع العظم: أمراض نخاع العظم تعتبر من أسباب ارتفاع كريات الدم البيضاء الأقل شيوعًا، وعند الإصابة بمرض سرطان الدم سيحدث ارتفاع في كريات الدم البيضاء، وأيضًا قد يحدث ارتفاع في كريات الدم البيضاء بسبب حدوث تليف في نخاع العظم.
أعراض ارتفاع كريات الدم البيضاء في الجسم
ارتفاع كريات الدم البيضاء سيؤدي إلى حدوث زيادة في كثافة الدم وبالتالي حدوث خلل في تدفق الدم إلى أعضاء الجسم مسببًا حدوث سكتة دماغية أو مشاكل في الرؤية أو مشاكل في التنفس أو نزيف من الفم والمعدة والأمعاء، وأيضًا قد تظهر العديد من الأعراض والذي يعتمد ظهورها على أسباب ارتفاع كريات الدم البيضاء في الجسم، وهذه الأعراض تشمل:[٦]
- الأعراض التي تظهر بسبب الالتهابات: ستظهر على المصاب العديد من الأعراض عندما تكون أسباب ارتفاع كريات الدم البيضاء في الجسم هي الالتهابات كالحمى أوالشعور بألم في مكان الالتهاب.
- الأعراض التي تظهر بسبب سرطان الدم: ستظهر على المريض العديد من الأعراض كالحمى أو سهولة التعرض لكدمات أو فقدان الوزن أو التعرق أثناء النوم.
- الأعراض التي تظهر بسبب رد الفعل التحسسي للجلد: ستظهر على المصاب العديد من الأعراض عند ارتفاع كريات الدم البيضاء بسبب رد الفعل التحسسي للجلد كظهور بقع حمراء على الجلد أو حدوث حكة في الجلد أو حدوث طفح جلدي.
- الأعراض التي تظهر بسبب رد الفعل التحسسي في الرئتين: ستظهر على المصاب العديد من الأعراض كخروج صوت صفير أثناء التنفس أو حدوث مشاكل في التنفس.
كيف يتم التحضير للكشف عن عدد كريات الدم البيضاء في الجسم
يتم الكشف عن عدد كريات الدم البيضاء في الجسم عن طريق اختبار تعداد كريات الدم البيضاء، ويساعد هذا الاختبار على معرفة ما إذا كان هناك انخفاض أو ارتفاع في عدد تلك الكريات، وسيقوم الطبيب بتحضير المريض للكشف عن عدد كريات الدم البيضاء في الجسم عن طريق إخباره بالتوقف عن تناول بعض الأدوية، والتي تشمل:[٧]
- الستيرويدات.
- الهيبارين.
- الكيندين.
- الكلوزابين.
- المضادات الحيوية.
- مضادات الهيستامين.
- مدرات البول.
- مضادات الصرع.
- السلفوناميدات.
- أدوية العلاج الكيمياوي.
كيف يتم الكشف عن عدد كريات الدم البيضاء في الجسم
يقوم مقدم الرعاية الصحية بالكشف عن عدد كريات الدم البيضاء في الجسم عن طريق ربط شريط مطاطي أعلى الذراع، وهذا الشريط يساعد على خروج الدم، ومن ثم يتم إدخال إبرة في الوريد لأخذ عينة من الدم وقد يؤدي إدخال الإبرة إلى حدوث إنزعاج بسيط، وسيقوم مقدم الرعاية الصحية بتنظيف مكان أخذ الدم ووضع شاش معقم بعد الانتهاء، وذلك لتجنب حدوث التهابات، وبعد ذلك سيقوم الطبيب بوضع الدم المسحوب في أنبوب خاص ومن ثم سيتم إرساله إلى المختبر لتحليله، وذلك لمعرفة عدد كريات الدم البيضاء في الجسم، وأيضًا لمعرفة أسباب ارتفاع كريات الدم البيضاء في الجسم.[٧]
مضاعفات الكشف عن عدد كريات الدم البيضاء في الجسم
اختبار عدد كريات الدم البيضاء في الجسم هو اختبار بسيط وعادةً لا يسبب حدوث أي مضاعفات، ولكن عند بعض الأشخاص قد يكون إجراء هذا الاختبار صعبًا وقد يسبب بعض المضاعفات، وخاصةً الأشخاص الذين يصعب تحديد مكان الوريد عندهم، ويوجد العديد من المضاعفات التي قد تحدث، وهي كالآتي:[٧]
تشخيص ارتفاع كريات الدم البيضاء في الجسم
زيادة عدد كريات الدم البيضاء عن 11000 خلية لكل ميكروليتر يكون دليل على وجود حالة مرضية، ويقوم الطبيب بالتشخيص لمعرفة أسباب ارتفاع كريات الدم البيضاء في الجسم، وبالتالي معرفة كيف يمكن علاجه، ويمكن تشخيص ارتفاع كريات الدم البيضاء في الجسم عن طريق استتخدام العديد من الاختبارات، وسيتم توضيح هذه الاختبارات، وهي كالآتي:[٦]
- اختبار تعداد الدم الكامل: يتم إجراء هذا الاختبار عن طريق أخذ عينة دم من خلال الوريد ومن ثم يتم تحليل هذه العينة لمعرفة عدد كريات الدم البيضاء في الجسم، وأيضًا يتم من خلال هذا الاختبار معرفة نسبة كل نوع من خلايا الدم البيضاء في الجسم.
- اختبار فحص الدم تحت المجهر: خلال هذا الاختبار يتم صبغ عينة من الدم ومن ثم يتم فحصها من خلال المجهر، وذلك لتحديد مستوى الخلايا اللمفاوية والعدلات في الدم.
- خزعة نخاع العظم: سيقوم الطبيب بإجراء هذا الاختبار عن طريق إدخال إبرة طويلة إلى نخاع العظم ومن ثم أخذ عينة لتحليلها، ويساعد هذا الاختبار على معرفة ما إذا كانت أسباب ارتفاع كريات الدم البيضاء في الجسم هي وجود أمراض في نخاع العظم أم لا.
علاج ارتفاع كريات الدم البيضاء في الجسم
عندما يسبب ارتفاع كريات الدم البيضاء حدوث متلازمة فرط لزوجة الدم فيتم علاج هذه المتلازمة من خلال إعطاء المريض سوائل عن طريق الوريد لتخفيف اللزوجة، وتجدر الإشارة إلى أن هذه المتلازمة مهددة للحياة، وعلاج ارتفاع كريات الدم البيضاء يعتمد بشكلٍ أساسي على أسباب ارتفاع كريات الدم البيضاء في الجسم، وسيتم توضيح كيف يمكن علاج هذا الارتفاع، والعلاج كالآتي:[٦]
- علاج الارتفاع الذي يحدث بسبب الالتهابات: يتم العلاج عن طريق استخدام المضادات الحيوية.
- علاج الارتفاع الذي يحدث بسبب الحساسية: يتم علاج هذا الارتفاع عن طريق استخدام الأدوية المضادة للهيستامين.
- علاج الارتفاع الذي يحدث بسبب سرطان الدم: يتم علاج هذا الارتفاع عن طريق استخدام العلاج الكيماوي أو العلاج الإشعاعي أو عن طريق زرع خلايا جذعية.
- علاج الارتفاع الذي يحدث بسبب رد الفعل التحسسي لبعض الأدوية: عندما يحدث ارتفاع كريات الدم البيضاء بسبب رد الفعل التحسسي لبعض الأدوية فيتم علاجه عن طريق التوقف عن استخدام تلك الأدوية أو تغييرها.
- علاج الارتفاع الذي يحدث بسبب التوتر والقلق: يتم علاج هذا الارتفاع والذي يحدث بسبب التوتر والقلق عن طريق علاج الأسباب التي تؤدي إلى حدوث التوتر والقلق.
- متلازمة فرط اللزوجة: وتعد هذه الحالة طارئة تستدعي التدخل الطبي العاجل لاعطاء المريض الأدوية والسوائل لخفض عدد كريات الدم البيضاء وبالتالي التقليل من اللزوجة والتي تعد حالة خطرة تعيق تدفق الدم بشكل طبيعي.
الوقاية من ارتفاع كريات الدم البيضاء في الجسم
أسباب ارتفاع كريات الدم البيضاء في الجسم عادةً لا تكون خطيرةً، ولكن في بعض الأحيان قد تكون خطيرةً، وخاصةً عندما يحدث هذا الارتفاع بسبب السرطان، ويمكن الوقاية من حدوث زيادة في عدد كريات الدم البيضاء في الجسم عن طريق اتباع العديد من الطرق، وسيتم توضيح هذه الطرق، وهي كالآتي:[٦]
- الحفاظ على النظافة العامة وغسل اليدين جيدًا، وذلك لتجنب حدوث الالتهابات.
- تجنب التعرض للمواد التي تسببب حدوث رد فعل تحسسي.
- الإقلاع عن التدخين، وذلك لتجنب حدوث ارتفاع كريات الدم البيضاء المرتبط بالتدخين، وأيضًا لتقليل خطر الإصابة بمرض السرطان.
- تجنب الأسباب التي تؤدي إلى حدوث التوتر.
- استشارة الطبيب قبل تناول الأدوية التي تعمل على علاج الالتهابات.
المراجع[+]
- ↑ "?How does blood work, and what problems occur", www.medicalnewstoday.com, Retrieved 15-10-2019. Edited.
- ↑ "Medical Definition of White blood cell", www.medicinenet.com, Retrieved 15-10-2019. Edited.
- ↑ "Types and Function of White Blood Cells WBCs", www.verywellhealth.com, Retrieved 15-10-2019. Edited.
- ↑ "High white blood cell count", www.mayoclinic.org, Retrieved 15-10-2019. Edited.
- ↑ "Causes of an Elevated White Blood Cell Count", www.livestrong.com, Retrieved 15-10-2019. Edited.
- ^ أ ب ت ث "?What Is Leukocytosis", www.healthline.com, Retrieved 15-10-2019. Edited.
- ^ أ ب ت "WBC (White Blood Cell) Count", www.healthline.com, Retrieved 15-10-2019. Edited.